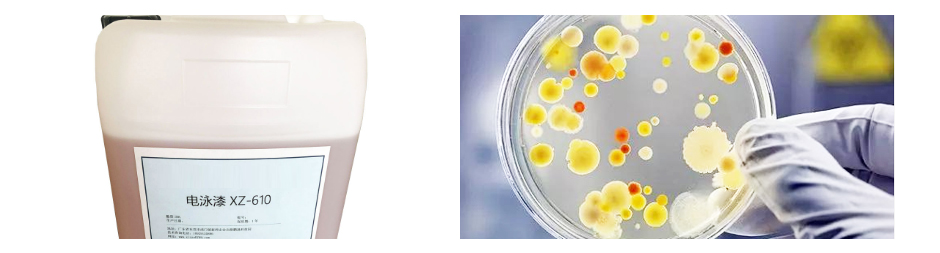

電泳漆生產純水設備解決方案
- 來源:
- 君浩環保集團
- 瀏覽:
- 2885
- 發布日期:
- 2023-06-24
使用純水設備的好處



產品特點:
1.去除懸浮顆粒和沉淀 2.除去溶解性離子 3.去除氣體 4.防止膜堵塞,保護RO膜 5.可降低能耗,節約資源

產品特點:
1.去除溶解性離子 2.去除微生物和病毒 3.提高水質 4.保障產水的穩定性 5.降低企業生產成本
電泳漆是一種高要求的涂料技術,對水質的要求較高。純水設備能夠去除水中的雜質和污染物,提供高質量、純凈的水源,確保電泳漆涂層的均勻性、附著力和外觀效果。
 生產用水標準
生產用水標準
1. 懸浮物和溶解物:水中的懸浮物和溶解物應控制在較低的水平,通常要求<5毫克/升,以確保涂層表面的光潔度和均勻性。
2. 鹽分含量:水中的鹽分含量對電泳漆的性能和涂層質量有直接影響。通常要求水中的總溶解固體(TDS)<100毫克/升,以避免離子的干擾,防止涂層出現氣泡、顆粒和沉積物等問題。
3. pH值:水的pH值對電泳漆的穩定性和反應速率具有影響。通常要求水的pH值在6.5-8.5之間,以確保電泳漆的正常工作和涂層的質量。
4. 微生物控制:水源中的微生物數量應控制在可接受的范圍內,以防止微生物引起的產品質量問題和衛生安全風險。常見的要求是水中的細菌總數和霉菌總數應<100個/毫升。
可根據客戶需求定制,出水達行業用水標準











 陜公網安備 61040202000640號
陜公網安備 61040202000640號